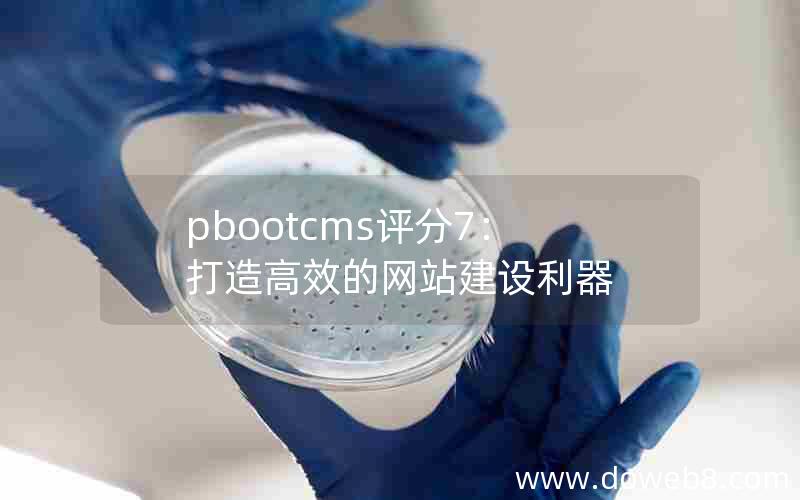
pbootcms评分7：打造高效的网站建设利器

-
- #建站教程 pbootcms自定义变量:打造个性化bootstrap组件
 本文介绍了pbootCMS自定义变量的使用方法,以实现个性化的Bootstrap组件。通过使用pbootCMS的自定义变量功能,用户可以灵活地调整Bootstrap组件的样式和布局,实现个性化的设计效果。本文详细介绍了如何使用pbootCMS的自定义变量功能,包括定义变量、修改变量值以及应用变量到B
本文介绍了pbootCMS自定义变量的使用方法,以实现个性化的Bootstrap组件。通过使用pbootCMS的自定义变量功能,用户可以灵活地调整Bootstrap组件的样式和布局,实现个性化的设计效果。本文详细介绍了如何使用pbootCMS的自定义变量功能,包括定义变量、修改变量值以及应用变量到B
-
- #建站教程 生物科技领域的创新展示:pbootcms生物科技PPT模板
 生物科技领域一直以来都是创新的热点,而pbootcms生物科技PPT模板则为我们展示了生物科技领域的创新成果。这个模板将生物科技与现代科技相结合,以简洁而专业的设计风格展现了生物科技领域的研究成果和创新发展。通过这个模板,我们可以清晰地了解到生物科技领域的最新进展,以及生物科技在医药、农业、环保等方
生物科技领域一直以来都是创新的热点,而pbootcms生物科技PPT模板则为我们展示了生物科技领域的创新成果。这个模板将生物科技与现代科技相结合,以简洁而专业的设计风格展现了生物科技领域的研究成果和创新发展。通过这个模板,我们可以清晰地了解到生物科技领域的最新进展,以及生物科技在医药、农业、环保等方
-
- #建站教程 pbootcms评分7:打造高效的网站建设利器
“pbootcms评分7:打造高效的网站建设利器”一文介绍了一款名为pbootcms的网站建设工具,该工具以其高效性和易用性受到了广泛的好评。文章中详细解析了pbootcms的功能和特点,包括其强大的模块化设计、丰富的插件扩展、灵活的模板管理等。作者还提到了pbootcms在网站建设过程中的优势,如
“pbootcms评分7:打造高效的网站建设利器”一文介绍了一款名为pbootcms的网站建设工具,该工具以其高效性和易用性受到了广泛的好评。文章中详细解析了pbootcms的功能和特点,包括其强大的模块化设计、丰富的插件扩展、灵活的模板管理等。作者还提到了pbootcms在网站建设过程中的优势,如
-
- #建站教程 pbootcms官网授权:解锁万能授权码,助您打造完美网站
 “pbootcms官网授权:解锁万能授权码,助您打造完美网站”是一篇介绍pbootcms官网授权服务的文章。该文章强调了pbootcms官网提供的万能授权码可以帮助用户打造出完美的网站。通过这个授权码,用户可以获得更多的功能和定制化选项,从而提升网站的表现和用户体验。这篇文章为读者提供了一个了解pb
“pbootcms官网授权:解锁万能授权码,助您打造完美网站”是一篇介绍pbootcms官网授权服务的文章。该文章强调了pbootcms官网提供的万能授权码可以帮助用户打造出完美的网站。通过这个授权码,用户可以获得更多的功能和定制化选项,从而提升网站的表现和用户体验。这篇文章为读者提供了一个了解pb
-
- #建站教程 pbootcms支付插件:实现便捷高效的网站支付功能
 pbootcms支付插件是一种功能强大的工具,能够为网站提供方便高效的支付功能。它允许网站***轻松地集成各种支付方式,如支付宝、微信支付等,为用户提供更多的支付选择。这个插件不仅简化了网站支付的流程,还提供了安全可靠的支付环境,确保用户的支付信息得到保护。通过pbootcms支付插件,网站可以实现
pbootcms支付插件是一种功能强大的工具,能够为网站提供方便高效的支付功能。它允许网站***轻松地集成各种支付方式,如支付宝、微信支付等,为用户提供更多的支付选择。这个插件不仅简化了网站支付的流程,还提供了安全可靠的支付环境,确保用户的支付信息得到保护。通过pbootcms支付插件,网站可以实现
-
- #建站教程 pbootcms模板网-专业收录与跳转
 “pbootcms模板网-专业收录与跳转”是一个致力于收录和跳转pbootcms模板的专业网站。该网站汇集了丰富多样的pbootcms模板资源,为用户提供了方便快捷的下载和使用渠道。无论你是个人站长还是企业开发者,无论你是初学者还是专业人士,这个网站都能满足你的需求。通过pbootcms模板网,你可
“pbootcms模板网-专业收录与跳转”是一个致力于收录和跳转pbootcms模板的专业网站。该网站汇集了丰富多样的pbootcms模板资源,为用户提供了方便快捷的下载和使用渠道。无论你是个人站长还是企业开发者,无论你是初学者还是专业人士,这个网站都能满足你的需求。通过pbootcms模板网,你可
-
- #建站教程 pbootcms模板-打造专属网站的利器
 “pbootcms模板-打造专属网站的利器”一文介绍了pbootcms模板的强大功能和优势,以及如何利用其打造个性化的网站。pbootcms模板是一款功能丰富、易于使用的网站建设工具,它提供了丰富的模板选择和定制化选项,使用户能够快速创建出专属于自己的网站。无论是企业网站、个人博客还是电子商务平台,
“pbootcms模板-打造专属网站的利器”一文介绍了pbootcms模板的强大功能和优势,以及如何利用其打造个性化的网站。pbootcms模板是一款功能丰富、易于使用的网站建设工具,它提供了丰富的模板选择和定制化选项,使用户能够快速创建出专属于自己的网站。无论是企业网站、个人博客还是电子商务平台,
-
- #建站教程 pbootcms顶部导航栏:Bootstrap顶部菜单栏
 “pbootcms顶部导航栏:Bootstrap顶部菜单栏”一文介绍了pbootcms系统中的顶部导航栏功能,该功能基于Bootstrap框架,提供了简洁美观的顶部菜单栏设计。全文详细介绍了如何在pbootcms系统中配置和使用顶部导航栏,包括添加菜单项、设置菜单样式和链接等。通过本文的指导,用户可
“pbootcms顶部导航栏:Bootstrap顶部菜单栏”一文介绍了pbootcms系统中的顶部导航栏功能,该功能基于Bootstrap框架,提供了简洁美观的顶部菜单栏设计。全文详细介绍了如何在pbootcms系统中配置和使用顶部导航栏,包括添加菜单项、设置菜单样式和链接等。通过本文的指导,用户可
-
- #建站教程 pbootcms附件下载权限:模板下载全攻略
 《pbootcms附件下载权限:模板下载全攻略》一文详细介绍了pbootcms系统中的附件下载权限设置以及模板下载的全面攻略。通过本文,读者可以了解到如何在pbootcms系统中设置附件下载权限,包括对不同用户角色的权限控制、对特定用户的个性化设置等。本文还提供了模板下载的全攻略,包括如何从pboo
《pbootcms附件下载权限:模板下载全攻略》一文详细介绍了pbootcms系统中的附件下载权限设置以及模板下载的全面攻略。通过本文,读者可以了解到如何在pbootcms系统中设置附件下载权限,包括对不同用户角色的权限控制、对特定用户的个性化设置等。本文还提供了模板下载的全攻略,包括如何从pboo
-
- #建站教程 pbootcms城市分站功能详解
 “pbootCMS城市分站功能详解”一文详细介绍了pbootCMS网站管理系统中的城市分站功能。该功能使网站***能够根据用户所在的城市自动定位并展示相应的内容,从而提升用户体验和网站的个性化服务。全文详细讲解了城市分站功能的实现原理和操作步骤,包括设置默认城市、添加城市列表、配置城市模板等。文章还
“pbootCMS城市分站功能详解”一文详细介绍了pbootCMS网站管理系统中的城市分站功能。该功能使网站***能够根据用户所在的城市自动定位并展示相应的内容,从而提升用户体验和网站的个性化服务。全文详细讲解了城市分站功能的实现原理和操作步骤,包括设置默认城市、添加城市列表、配置城市模板等。文章还






